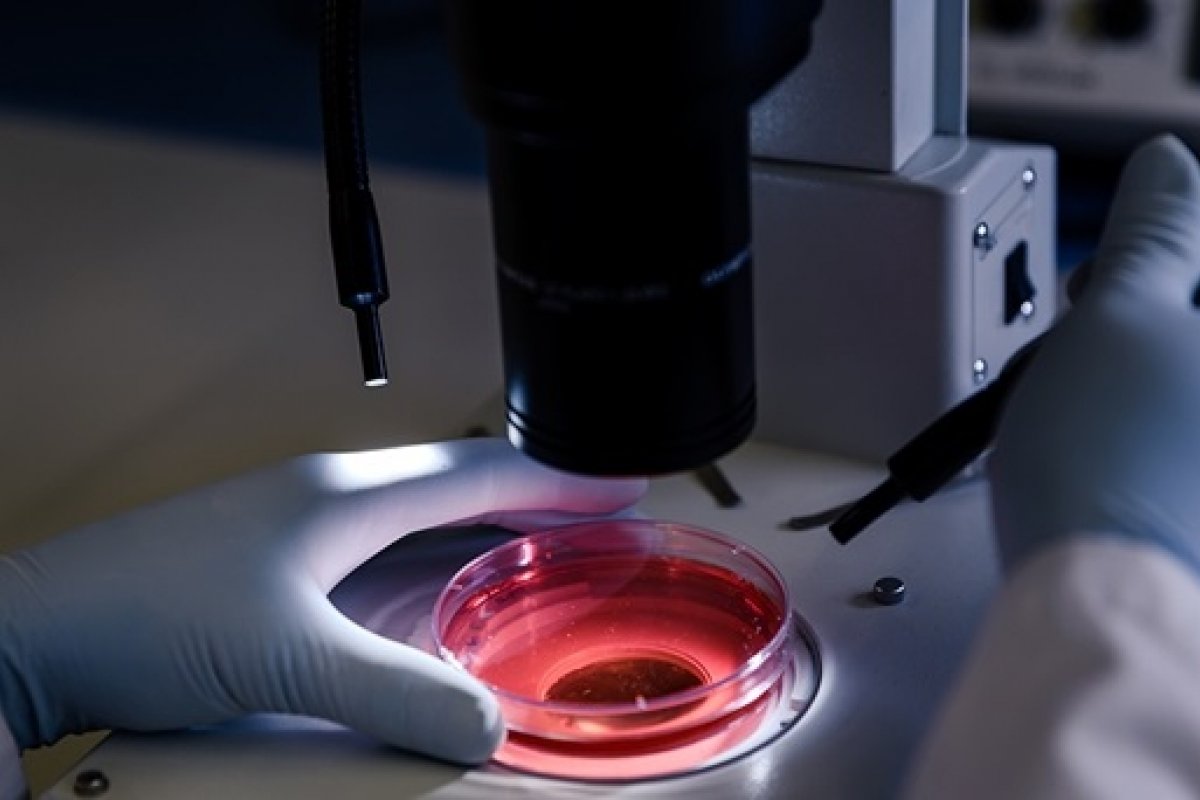

Anvisa suspende estudo com plasma de cordão umbilical contra a covid-19
Decisão foi tomada por causa de evento adverso
Foto: Divulgação | CellPraxis
A Agência Nacional de Vigilância Sanitária (Anvisa) suspendeu testes de um estudo que utiliza plasma do cordão umbilical humano contra a covid-19. As análises estavam sendo feitas pelo Hospital Alemão Oswaldo Cruz, em São Paulo.
De acordo com a Anvisa, a decisão foi tomada por causa de um evento adverso comunicado para a agência na última terça (17). A Anvisa não detalhou sobre o que se trata o evento adverso.
A Anvisa também destacou que "esse tipo de interrupção faz parte dos procedimentos de Boas Práticas Clínicas esperadas para estudos clínicos conduzidos no Brasil".


